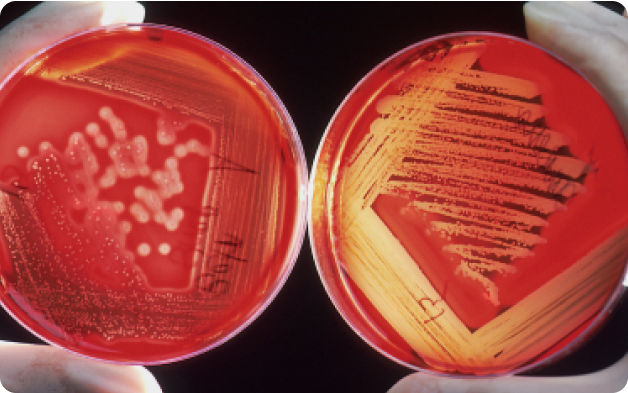
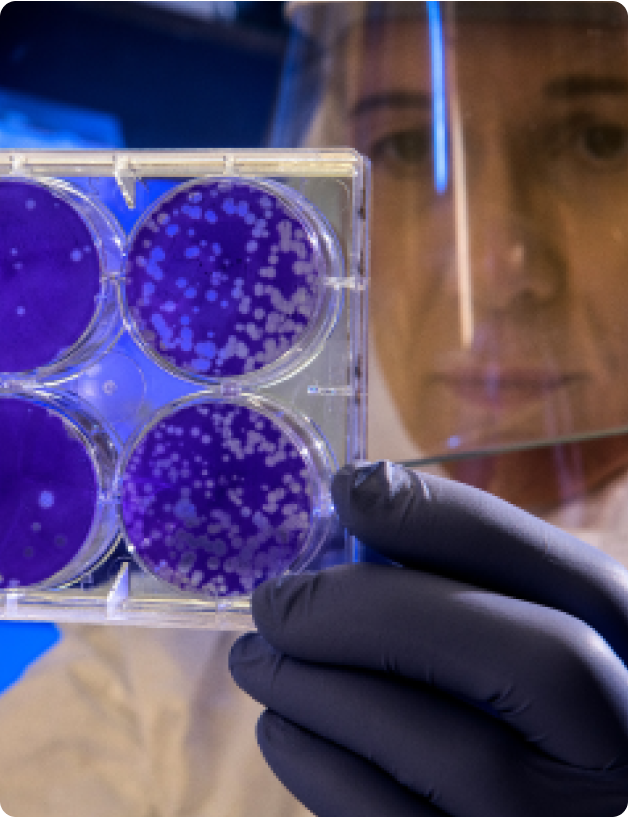

“I use FiftyOne on a daily basis to improve the quality of our data and visually inspect model predictions.”
Marijn Lems
Machine Learning Engineer, Aidence
“We use FiftyOne’s CVAT integration to request and load annotations from doctors, and compare them to the models’ predictions. Using FiftyOne’s embeddings visualization, we get a better understanding of our data distribution and identify the most unique images by eliminating near duplicates.”
Oğuz Hanoğlu
PhD Candidate/Engineer, Multimedia Informatics
